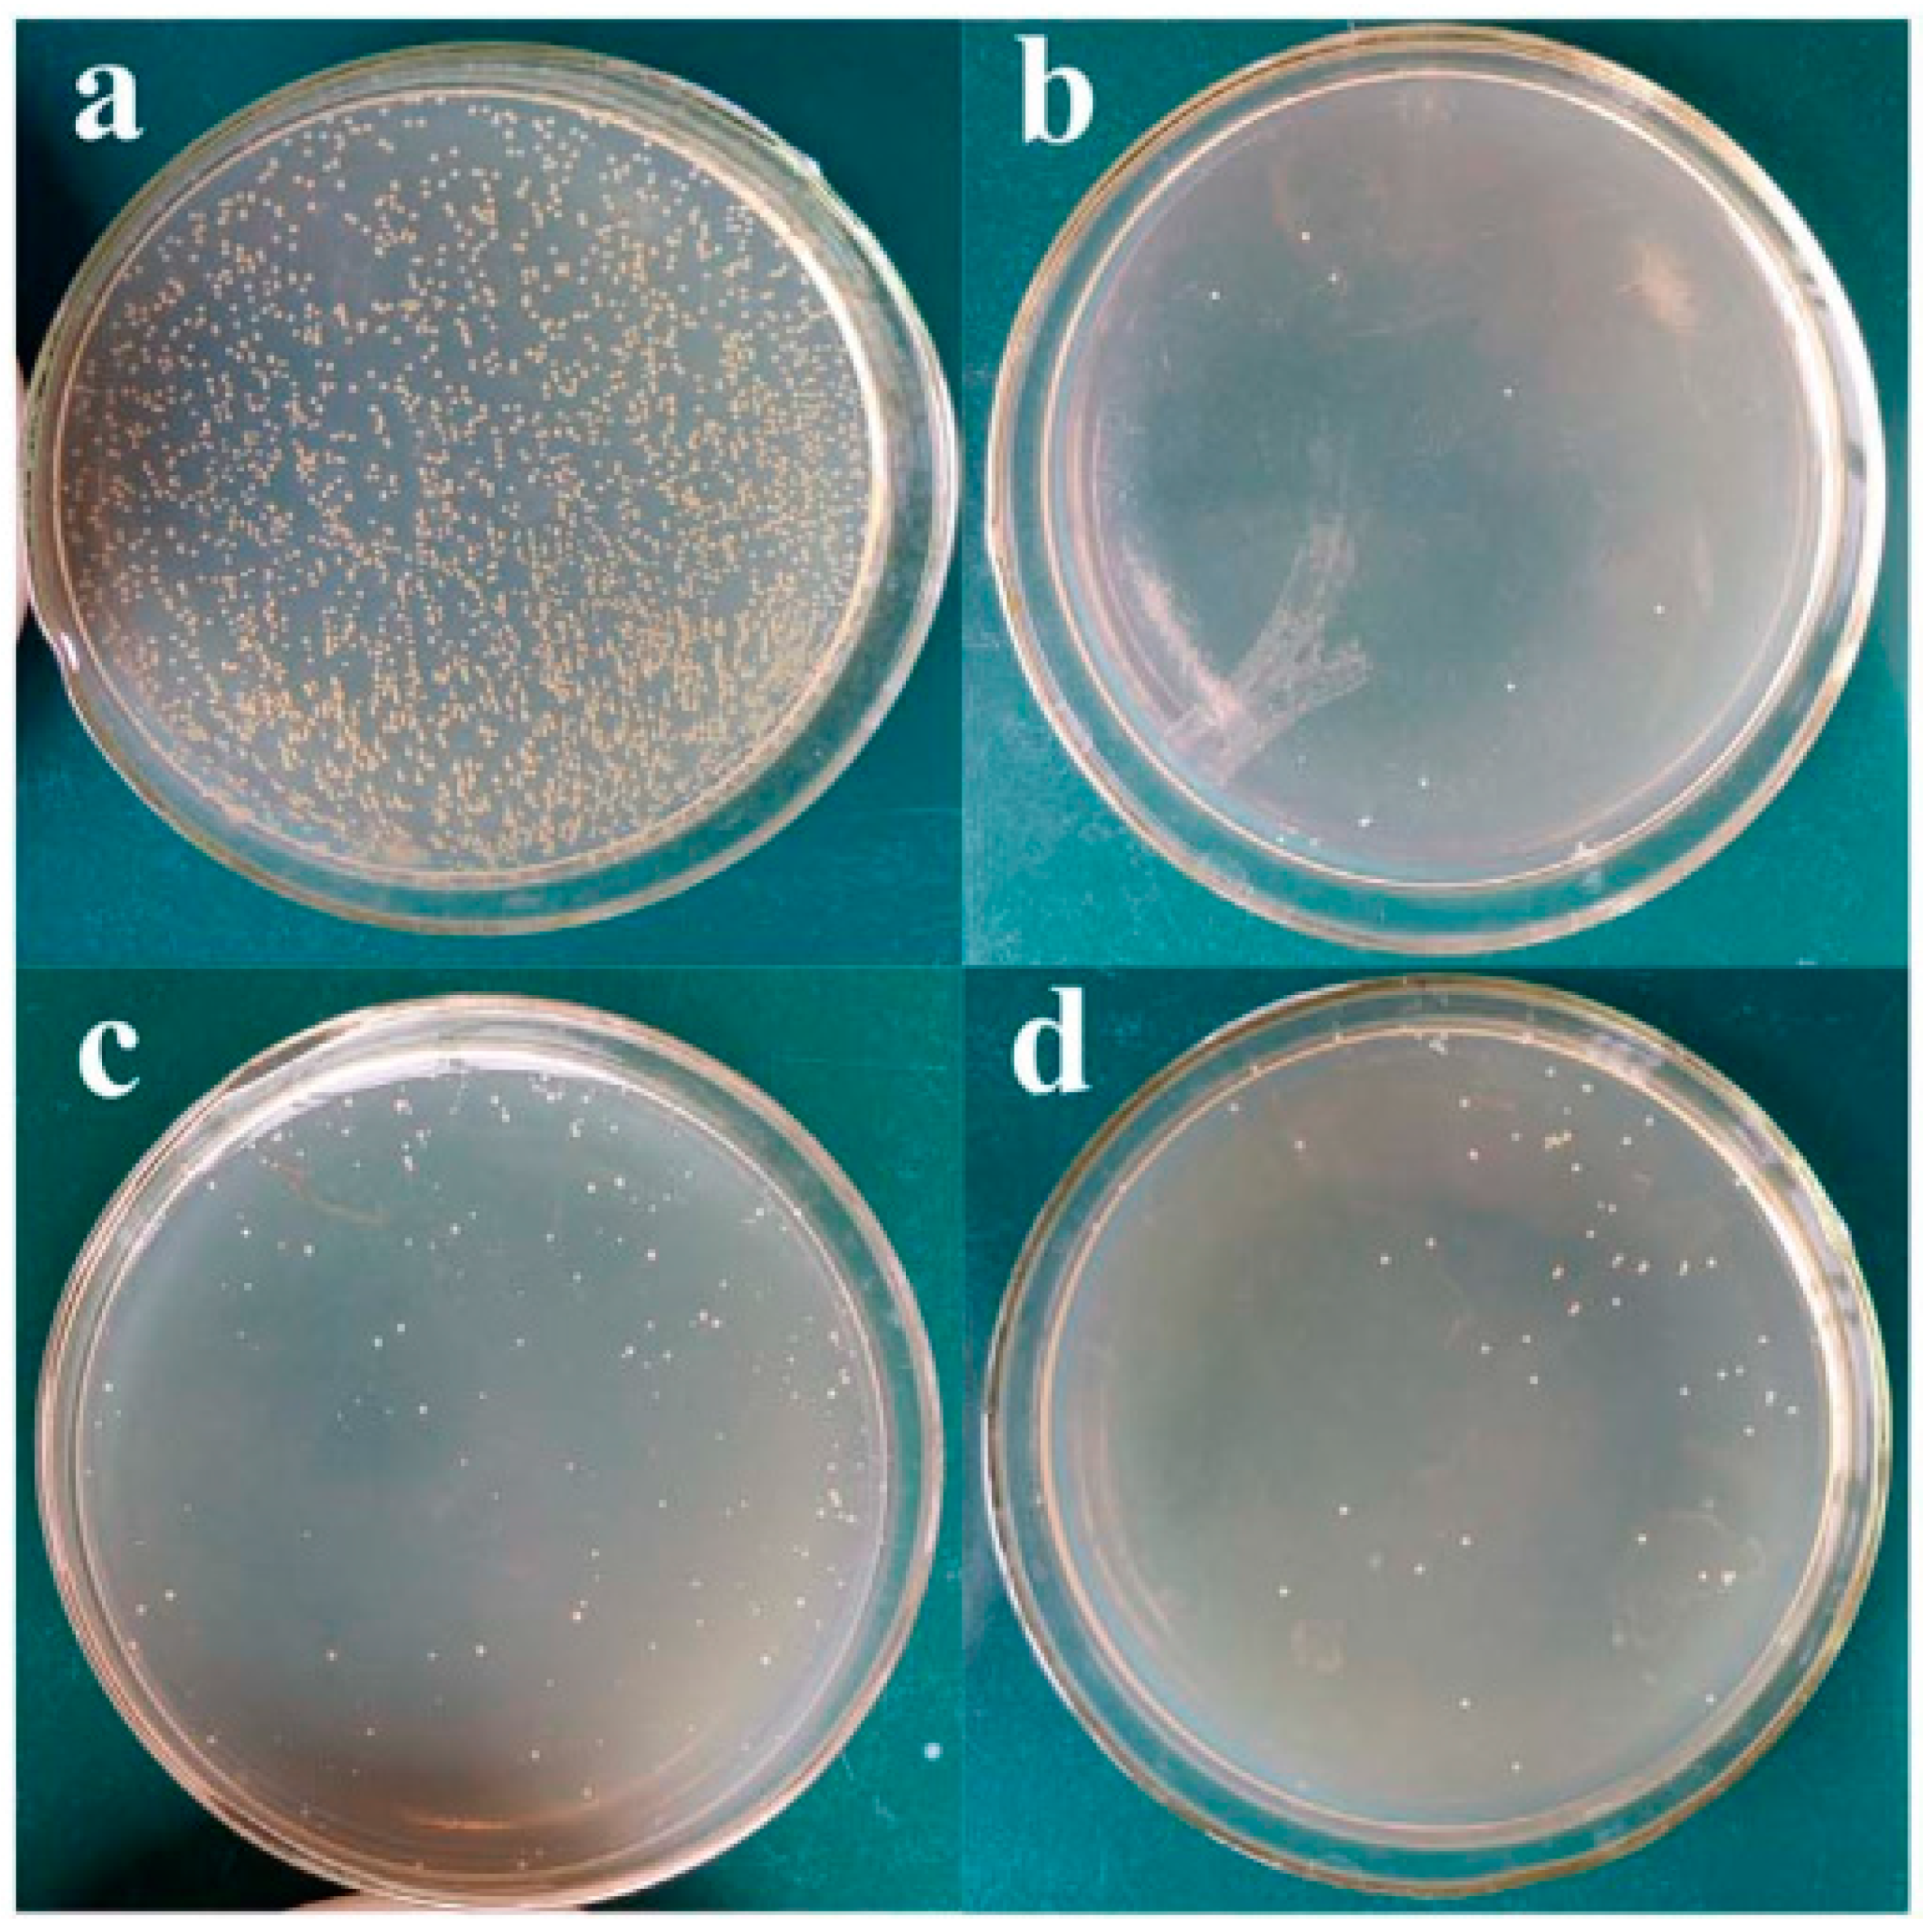
Jfb 13 00267 g011 Jfb 13 00267 g011

Performance of PEO/Polymer Coatings on the Biodegradability, Antibacterial Effect and Biocompatibility of Mg-Based Materials
Abstract
1. Introduction
2. Properties of Mg and Its Alloys: Challenges and Solutions
3. PEO Process
4. Surface Properties of the Composite (PEO/Polymer) Coatings on Magnesium Alloys
5. Biocorrosion Behavior of the Composite (PEO/Polymer) Coatings on Magnesium Alloys
6. Biocompatible Behavior of the Composite (PEO/Polymer) Coatings on Magnesium Alloys
7. Conclusions
Funding
Institutional Review Board Statement
Informed Consent Statement
Data Availability Statement
Conflicts of Interest
References
- Ghosh, S.; Sanghavi, S.; Sancheti, P. Metallic biomaterial for bone support and replacement. In Fundamental Biomaterials: Metals; Elsevier: Amsterdam, The Netherlands, 2018; pp. 139–165. [Google Scholar]
- Chen, Q.; Thouas, G.A. Metallic implant biomaterials. Mater. Sci. Eng. R Rep. 2015, 87, 1–57. [Google Scholar] [CrossRef]
- Geetha, M.; Singh, A.K.; Asokamani, R.; Gogia, A.K. Ti based biomaterials, the ultimate choice for orthopaedic implants—A review. Prog. Mater. Sci. 2009, 54, 397–425. [Google Scholar] [CrossRef]
- Peterson, D.R.; Bronzino, J.D. (Eds.) Biomechanics; CRC Press: Boca Raton, FL, USA, 2007; ISBN 9780429126970. [Google Scholar]
- Kabir, H.; Munir, K.; Wen, C.; Li, Y. Recent research and progress of biodegradable zinc alloys and composites for biomedical applications: Biomechanical and biocorrosion perspectives. Bioact. Mater. 2021, 6, 836–879. [Google Scholar] [CrossRef] [PubMed]
- Fattah-alhosseini, A.; Chaharmahali, R.; Babaei, K.; Nouri, M.; Keshavarz, M.K.; Kaseem, M. A review of effective strides in amelioration of the biocompatibility of PEO coatings on Mg alloys. J. Magnes. Alloy. 2022, 10, 2354–2383. [Google Scholar] [CrossRef]
- Lane, J.M.; Mait, J.E.; Unnanuntana, A.; Hirsch, B.P.; Shaffer, A.D.; Shonuga, O.A. Materials in Fracture Fixation. In Comprehensive Biomaterials; Elsevier: Amsterdam, The Netherlands, 2011; pp. 219–235. [Google Scholar]
- Agarwal, S.; Curtin, J.; Duffy, B.; Jaiswal, S. Biodegradable magnesium alloys for orthopaedic applications: A review on corrosion, biocompatibility and surface modifications. Mater. Sci. Eng. C 2016, 68, 948–963. [Google Scholar] [CrossRef]
- Yang, Y.; He, C.; Dianyu, E.; Yang, W.; Qi, F.; Xie, D.; Shen, L.; Peng, S.; Shuai, C. Mg bone implant: Features, developments and perspectives. Mater. Des. 2020, 185, 108259. [Google Scholar] [CrossRef]
- Zhou, H.; Liang, B.; Jiang, H.; Deng, Z.; Yu, K. Magnesium-based biomaterials as emerging agents for bone repair and regeneration: From mechanism to application. J. Magnes. Alloy. 2021, 9, 779–804. [Google Scholar] [CrossRef]
- Staiger, M.P.; Pietak, A.M.; Huadmai, J.; Dias, G. Magnesium and its alloys as orthopedic biomaterials: A review. Biomaterials 2006, 27, 1728–1734. [Google Scholar] [CrossRef]
- Myrissa, A.; Ahmad, N.; Lu, Y.; Martinelli, E.; Eichler, J.; Szakács, G.; Kleinhans, C.; Willumeit-römer, R.; Schäfer, U.; Weinberg, A. In vitro and in vivo comparison of binary Mg alloys and pure Mg. Mater. Sci. Eng. C 2016, 61, 865–874. [Google Scholar] [CrossRef]
- Yun, Y.; Dong, Z.; Yang, D.; Schulz, M.J.; Shanov, V.N.; Yarmolenko, S.; Xu, Z.; Kumta, P.; Sfeir, C. Biodegradable Mg corrosion and osteoblast cell culture studies. Mater. Sci. Eng. C 2009, 29, 1814–1821. [Google Scholar] [CrossRef]
- Prakasam, M.; Locs, J.; Salma-Ancane, K.; Loca, D.; Largeteau, A.; Berzina-Cimdina, L. Biodegradable materials and metallic implants-A review. J. Funct. Biomater. 2017, 8, 44. [Google Scholar] [CrossRef]
- Saini, M. Implant biomaterials: A comprehensive review. World J. Clin. Cases 2015, 3, 52. [Google Scholar] [CrossRef] [PubMed]
- Zheng, Y.F.; Gu, X.N.; Witte, F. Biodegradable metals. Mater. Sci. Eng. R Rep. 2014, 77, 1–34. [Google Scholar] [CrossRef]
- Niu, J.; Xiong, M.; Guan, X.; Zhang, J.; Huang, H.; Pei, J. The in vivo degradation and bone-implant interface of Mg-Nd-Zn-Zr alloy screws: 18 months post-operation results. Eval. Program Plann. 2016, 113, 183–187. [Google Scholar] [CrossRef]
- Matsushita, T.; Takahashi, H. Orthopedic Applications of Metallic Biomaterials, 2nd ed.Elsevier Ltd.: Amsterdam, The Netherlands, 2019; ISBN 9780081026663. [Google Scholar]
- Kaseem, M.; Zehra, T.; Dikici, B.; Dafali, A.; Yang, H.W.; Ko, Y.G. Improving the electrochemical stability of AZ31 Mg alloy in a 3.5wt.% NaCl solution via the surface functionalization of plasma electrolytic oxidation coating. J. Magnes. Alloy. 2021, 10, 1311–1325. [Google Scholar] [CrossRef]
- Kaseem, M.; Ko, Y.G. Morphological modification and corrosion response of MgO and Mg3(PO4)2 composite formed on magnesium alloy. Compos. Part B Eng. 2019, 176, 107225. [Google Scholar] [CrossRef]
- Mohedano, M.; Luthringer, B.J.C.; Mingo, B.; Feyerabend, F.; Arrabal, R.; Sanchez-egido, P.J.; Blawert, C. Surface & Coatings Technology Bioactive plasma electrolytic oxidation coatings on Mg-Ca alloy to control degradation behaviour. Surf. Coat. Technol. 2017, 315, 454–467. [Google Scholar]
- Helvia, A.; Sanchez, M.; Luthringer, B.J.C.; Feyerabend, F.; Willumeit, R. Acta Biomaterialia Mg and Mg alloys: How comparable are in vitro and in vivo corrosion rates ? A review. Acta Biomater. 2015, 13, 16–31. [Google Scholar]
- Wilke, B.M.; Zhang, L.; Li, W.; Ning, C.; Chen, C.F.; Gu, Y. Corrosion performance of MAO coatings on AZ31 Mg alloy in simulated body fluid vs. Earle’s Balance Salt Solution. Appl. Surf. Sci. 2016, 363, 328–337. [Google Scholar] [CrossRef]
- Fattah-alhosseini, A.; Chaharmahali, R. Enhancing corrosion and wear performance of PEO coatings on Mg alloys using graphene and graphene oxide additions: A review. FlatChem 2021, 27, 100241. [Google Scholar] [CrossRef]
- Liu, H.; Cao, F.; Song, G.-L.; Zheng, D.; Shi, Z.; Dargusch, M.S.; Atrens, A. Review of the atmospheric corrosion of magnesium alloys. J. Mater. Sci. Technol. 2019, 35, 2003–2016. [Google Scholar] [CrossRef]
- Hu, R.-G.; Zhang, S.; Bu, J.-F.; Lin, C.-J.; Song, G.-L. Recent progress in corrosion protection of magnesium alloys by organic coatings. Prog. Org. Coatings 2012, 73, 129–141. [Google Scholar] [CrossRef]
- Witte, F.; Feyerabend, F.; Maier, P.; Fischer, J.; Störmer, M.; Blawert, C.; Dietzel, W.; Hort, N. Biodegradable magnesium–hydroxyapatite metal matrix composites. Biomaterials 2007, 28, 2163–2174. [Google Scholar] [CrossRef] [PubMed]
- Chen, X.-B.; Easton, M.A.; Birbilis, N.; Yang, H.-Y.; Abbott, T.B. Corrosion-resistant electrochemical plating of magnesium (Mg) alloys. In Corrosion Prevention of Magnesium Alloys; Elsevier: Amsterdam, The Netherlands, 2013; pp. 315–346. [Google Scholar]
- Gray, J.E.; Luan, B. Protective coatings on magnesium and its alloys—A critical review. J. Alloys Compd. 2002, 336, 88–113. [Google Scholar] [CrossRef]
- Tian, P.; Liu, X. Surface modification of biodegradable magnesium and its alloys for biomedical applications. Regen. Biomater. 2015, 2, 135–151. [Google Scholar] [CrossRef] [PubMed]
- Thakur, A.; Gharde, S.; Kandasubramanian, B. Electroless nickel fabrication on surface modified magnesium substrates. Def. Technol. 2019, 15, 636–644. [Google Scholar] [CrossRef]
- Ambat, R.; Zhou, W. Electroless nickel-plating on AZ91D magnesium alloy: Effect of substrate microstructure and plating parameters. Surf. Coat. Technol. 2004, 179, 124–134. [Google Scholar] [CrossRef]
- Wu, L.; Zhao, J.; Xie, Y.; Yang, Z. Progress of electroplating and electroless plating on magnesium alloy. Trans. Nonferrous Met. Soc. China 2010, 20, s630–s637. [Google Scholar] [CrossRef]
- Brunelli, K.; Dabalà, M.; Calliari, I.; Magrini, M. Effect of HCl pre-treatment on corrosion resistance of cerium-based conversion coatings on magnesium and magnesium alloys. Corros. Sci. 2005, 47, 989–1000. [Google Scholar] [CrossRef]
- Saji, V.S. Organic conversion coatings for magnesium and its alloys. J. Ind. Eng. Chem. 2019, 75, 20–37. [Google Scholar] [CrossRef]
- Sivapragash, M.; Kumaradhas, P.; Vettivel, S.C.; Retnam, B.S.J. Optimization of PVD process parameter for coating AZ91D magnesium alloy by Taguchi grey approach. J. Magnes. Alloy. 2018, 6, 171–179. [Google Scholar] [CrossRef]
- Zhang, D.; Qi, Z.; Wei, B.; Wang, Z. Low temperature thermal oxidation towards hafnium-coated magnesium alloy for biomedical application. Mater. Lett. 2017, 190, 181–184. [Google Scholar] [CrossRef]
- Thirumalaikumarasamy, D.; Balasubramanian, V.; Sree Sabari, S. Prediction and optimization of process variables to maximize the Young’s modulus of plasma sprayed alumina coatings on AZ31B magnesium alloy. J. Magnes. Alloy. 2017, 5, 133–145. [Google Scholar] [CrossRef]
- Zhang, Y.; Tang, S.; Hu, J.; Lin, T. Formation mechanism and corrosion resistance of the hydrophobic coating on anodized magnesium. Corros. Sci. 2016, 111, 334–343. [Google Scholar] [CrossRef]
- Jeong, H.; Cho, J. Characterization of interfacial layers grown between magnesium substrates and SiO films deposited by plasma-enhanced CVD. Surf. Coat. Technol. 2017, 332, 105–111. [Google Scholar] [CrossRef]
- Nakatani, T.; Takeuchi, H.; Wada, A.; Yamashita, S. Investigation of Anti-Corrosive Performance of a Si-Doped DLC-Coated Magnesium Alloy Stent Deposited by RF-Plasma CVD. J. Photopolym. Sci. Technol. 2019, 32, 511–517. [Google Scholar] [CrossRef]
- Chen, Y.; Lu, X.; Lamaka, S.V.; Ju, P.; Blawert, C.; Zhang, T.; Wang, F.; Zheludkevich, M.L. Active protection of Mg alloy by composite PEO coating loaded with corrosion inhibitors. Appl. Surf. Sci. 2020, 504, 144462. [Google Scholar] [CrossRef]
- Chaharmahali, R.; Fattah-alhosseini, A.; Esfahani, H. Increasing the in-vitro corrosion resistance of AZ31B-Mg alloy via coating with hydroxyapatite using plasma electrolytic oxidation. J. Asian Ceram. Soc. 2020, 8, 39–49. [Google Scholar] [CrossRef]
- White, L.; Koo, Y.; Neralla, S.; Sankar, J.; Yun, Y. Enhanced mechanical properties and increased corrosion resistance of a biodegradable magnesium alloy by plasma electrolytic oxidation (PEO). Mater. Sci. Eng. B 2016, 208, 39–46. [Google Scholar] [CrossRef]
- Farhadi, S.S.; Aliofkhazraei, M.; Barati Darband, G.; Abolhasani, A.; Sabour Rouhaghdam, A. Corrosion and wettability of PEO coatings on magnesium by addition of potassium stearate. J. Magnes. Alloy. 2017, 5, 210–216. [Google Scholar] [CrossRef]
- Kaseem, M.; Choe, H.-C. The effect of in-situ reactive incorporation of MoOx on the corrosion behavior of Ti-6Al-4 V alloy coated via micro-arc oxidation coating. Corros. Sci. 2021, 192, 109764. [Google Scholar] [CrossRef]
- Ali, M.; Hussein, M.A.; Al-Aqeeli, N. Magnesium-based composites and alloys for medical applications: A review of mechanical and corrosion properties. J. Alloys Compd. 2019, 792, 1162–1190. [Google Scholar] [CrossRef]
- Chaharmahali, R.; Fattah-alhosseini, A.; Babaei, K. Surface characterization and corrosion behavior of calcium phosphate (Ca-P) base composite layer on Mg and its alloys using plasma electrolytic oxidation (PEO): A review. J. Magnes. Alloy. 2020, 9, 21–40. [Google Scholar] [CrossRef]
- Zehra, T.; Patil, S.A.; Shrestha, N.K.; Fattah-alhosseini, A.; Kaseem, M. Anionic assisted incorporation of WO3 nanoparticles for enhanced electrochemical properties of AZ31 Mg alloy coated via plasma electrolytic oxidation. J. Alloys Compd. 2022, 916, 165445. [Google Scholar] [CrossRef]
- Toorani, M.; Aliofkhazraei, M.; Mahdavian, M.; Naderi, R. Superior corrosion protection and adhesion strength of epoxy coating applied on AZ31 magnesium alloy pre-treated by PEO/Silane with inorganic and organic corrosion inhibitors. Corros. Sci. 2021, 178, 109065. [Google Scholar] [CrossRef]
- Chaharmahali, R.; Fattah-alhosseini, A.; Nouri, M.; Babaei, K. Improving surface characteristics of PEO coatings of Mg and its alloys with zirconia nanoparticles: A review. Appl. Surf. Sci. Adv. 2021, 6, 100131. [Google Scholar] [CrossRef]
- Sankara Narayanan, T.S.N.; Park, I.S.; Lee, M.H. Strategies to improve the corrosion resistance of microarc oxidation (MAO) coated magnesium alloys for degradable implants: Prospects and challenges. Prog. Mater. Sci. 2014, 60, 1–71. [Google Scholar] [CrossRef]
- Tang, H.; Wu, T.; Wang, H.; Jian, X.; Wu, Y. Corrosion behavior of HA containing ceramic coated magnesium alloy in Hank ’ s solution. J. Alloys Compd. 2017, 698, 643–653. [Google Scholar] [CrossRef]
- Mordike, B.L.; Ebert, T. Magnesium Properties-applications-potential. Mater. Sci. Eng. A 2001, 302, 37–45. [Google Scholar] [CrossRef]
- Hornberger, H.; Virtanen, S.; Boccaccini, A.R. Acta Biomaterialia Biomedical coatings on magnesium alloys—A review. Acta Biomater. 2012, 8, 2442–2455. [Google Scholar] [CrossRef]
- Kaseem, M.; Ko, Y.G. A novel hybrid composite composed of albumin, WO3, and LDHs film for smart corrosion protection of Mg alloy. Compos. Part B Eng. 2021, 204, 108490. [Google Scholar] [CrossRef]
- Ivanou, D.K.; Starykevich, M.; Lisenkov, A.D.; Zheludkevich, M.L.; Xue, H.B.; Lamaka, S.V.; Ferreira, M.G.S. Plasma anodized ZE41 magnesium alloy sealed with hybrid epoxy-silane coating. Corros. Sci. 2013, 73, 300–308. [Google Scholar] [CrossRef]
- Castellanos, A.; Altube, A.; Vega, J.M.; García-Lecina, E.; Díez, J.A.; Grande, H.J. Effect of different post-treatments on the corrosion resistance and tribological properties of AZ91D magnesium alloy coated PEO. Surf. Coat. Technol. 2015, 278, 99–107. [Google Scholar] [CrossRef]
- Arrabal, R.; Mota, J.M.; Criado, A.; Pardo, A.; Mohedano, M.; Matykina, E. Assessment of duplex coating combining plasma electrolytic oxidation and polymer layer on AZ31 magnesium alloy. Surf. Coat. Technol. 2012, 206, 4692–4703. [Google Scholar] [CrossRef]
- Shi, P.; Ng, W.F.; Wong, M.H.; Cheng, F.T. Improvement of corrosion resistance of pure magnesium in Hanks’ solution by microarc oxidation with sol–gel TiO2 sealing. J. Alloys Compd. 2009, 469, 286–292. [Google Scholar] [CrossRef]
- Malayoglu, U.; Tekin, K.C.; Shrestha, S. Influence of post-treatment on the corrosion resistance of PEO coated AM50B and AM60B Mg alloys. Surf. Coat. Technol. 2010, 205, 1793–1798. [Google Scholar] [CrossRef]
- Lamaka, S.V.; Knörnschild, G.; Snihirova, D.V.; Taryba, M.G.; Zheludkevich, M.L.; Ferreira, M.G.S. Complex anticorrosion coating for ZK30 magnesium alloy. Electrochim. Acta 2009, 55, 131–141. [Google Scholar] [CrossRef]
- Li, Z.; Jing, X.; Yuan, Y.; Zhang, M. Composite coatings on a Mg–Li alloy prepared by combined plasma electrolytic oxidation and sol–gel techniques. Corros. Sci. 2012, 63, 358–366. [Google Scholar] [CrossRef]
- Fattah-alhosseini, A.; Chaharmahali, R.; Babaei, K. Impressive strides in amelioration of corrosion and wear behaviors of Mg alloys using applied polymer coatings on PEO porous coatings: A review. J. Magnes. Alloy. 2022, 10, 1171–1190. [Google Scholar] [CrossRef]
- Zucchi, F.; Frignani, A.; Grassi, V.; Balbo, A.; Trabanelli, G. Organo-silane coatings for AZ31 magnesium alloy corrosion protection. Mater. Chem. Phys. 2008, 110, 263–268. [Google Scholar] [CrossRef]
- Mei, D.; Lamaka, S.V.; Lu, X.; Zheludkevich, M.L. Selecting medium for corrosion testing of bioabsorbable magnesium and other metals—A critical review. Corros. Sci. 2020, 171, 108722. [Google Scholar] [CrossRef]
- Hou, L.; Li, Z.; Pan, Y.; Du, L.; Li, X.; Zheng, Y.; Li, L. In vitro and in vivo studies on biodegradable magnesium alloy. Prog. Nat. Sci. Mater. Int. 2014, 24, 466–471. [Google Scholar] [CrossRef]
- Pulido-González, N.; Torres, B.; Rodrigo, P.; Hort, N.; Rams, J. Microstructural, mechanical and corrosion characterization of an as-cast Mg–3Zn–0.4Ca alloy for biomedical applications. J. Magnes. Alloy. 2020, 8, 510–522. [Google Scholar] [CrossRef]
- Rahman, M.; Li, Y.; Wen, C. HA coating on Mg alloys for biomedical applications: A review. J. Magnes. Alloy. 2020, 8, 929–943. [Google Scholar] [CrossRef]
- Ali, M.; Elsherif, M.; Salih, A.E.; Ul-Hamid, A.; Hussein, M.A.; Park, S.; Yetisen, A.K.; Butt, H. Surface modification and cytotoxicity of Mg-based bio-alloys: An overview of recent advances. J. Alloys Compd. 2020, 825, 154140. [Google Scholar] [CrossRef]
- Li, J.; Jansen, J.A.; Walboomers, X.F.; van den Beucken, J.J. Mechanical aspects of dental implants and osseointegration: A narrative review. J. Mech. Behav. Biomed. Mater. 2020, 103, 103574. [Google Scholar] [CrossRef]
- Brar, H.S.; Wong, J.; Manuel, M.V. Investigation of the mechanical and degradation properties of Mg–Sr and Mg–Zn–Sr alloys for use as potential biodegradable implant materials. J. Mech. Behav. Biomed. Mater. 2012, 7, 87–95. [Google Scholar] [CrossRef]
- Liu, L.; Yu, H.; Yang, W.; Wang, Z. Inhibition of grain growth by a Ce-rich precipitate during the annealing of spray-casted magnesium alloy. Materials 2019, 12, 742. [Google Scholar] [CrossRef]
- Ghasali, E.; Bordbar-Khiabani, A.; Alizadeh, M.; Mozafari, M.; Niazmand, M.; Kazemzadeh, H.; Ebadzadeh, T. Corrosion behavior and in-vitro bioactivity of porous Mg/Al2O3 and Mg/Si3N4 metal matrix composites fabricated using microwave sintering process. Mater. Chem. Phys. 2019, 225, 331–339. [Google Scholar] [CrossRef]
- Amukarimi, S.; Mozafari, M. Biodegradable magnesium-based biomaterials: An overview of challenges and opportunities. MedComm 2021, 2, 123–144. [Google Scholar] [CrossRef]
- Tian, J.; Luo, Z.; Qi, S.; Sun, X. Structure and antiwear behavior of micro-arc oxidized coatings on aluminum alloy. Surf. Coat. Technol. 2002, 154, 1–7. [Google Scholar] [CrossRef]
- AN, L.; MA, Y.; YAN, X.; WANG, S.; WANG, Z. Effects of electrical parameters and their interactions on plasma electrolytic oxidation coatings on aluminum substrates. Trans. Nonferrous Met. Soc. China 2020, 30, 883–895. [Google Scholar] [CrossRef]
- Chen, F.; Zhang, Y.; Zhang, Y. Effect of Graphene on Micro-Structure and Properties of MAO Coating Prepared on Mg-Li Alloy. Int. J. Electrochem. Sci. 2017, 12, 6081–6091. [Google Scholar] [CrossRef]
- Li, X.; Liu, X.; Wu, S.; Yeung, K.W.K.; Zheng, Y.; Chu, P.K. Design of magnesium alloys with controllable degradation for biomedical implants: From bulk to surface. Acta Biomater. 2016, 45, 2–30. [Google Scholar] [CrossRef]
- Fattah-alhosseini, A.; Chaharmahali, R.; Babaei, K. Effect of particles addition to solution of plasma electrolytic oxidation (PEO) on the properties of PEO coatings formed on magnesium and its alloys: A review. J. Magnes. Alloy. 2020, 8, 799–818. [Google Scholar] [CrossRef]
- Hafili, F.; Chaharmahali, R.; Babaei, K.; Fattah-alhosseini, A. Duty cycle influence on the corrosion behavior of coatings created by plasma electrolytic oxidation on AZ31B magnesium alloy in simulated body fluid. Corros. Commun. 2021, 3, 62–70. [Google Scholar] [CrossRef]
- Attarzadeh, N.; Ramana, C.V. Plasma Electrolytic Oxidation Ceramic Coatings on Zirconium (Zr) and ZrAlloys: Part I—Growth Mechanisms, Microstructure, and Chemical Composition. Coatings 2021, 11, 634. [Google Scholar] [CrossRef]
- Attarzadeh, N.; Ramana, C.V. Plasma Electrolytic Oxidation Ceramic Coatings on Zirconium (Zr) and Zr-Alloys: Part-II: Properties and Applications. Coatings 2021, 11, 620. [Google Scholar] [CrossRef]
- Fattah-alhosseini, A.; Chaharmahali, R.; Keshavarz, M.K.; Babaei, K. Surface characterization of bioceramic coatings on Zr and its alloys using plasma electrolytic oxidation (PEO): A review. Surf. Interfaces 2021, 25, 101283. [Google Scholar] [CrossRef]
- Walsh, F.C.; Low, C.T.J.; Wood, R.J.K.; Stevens, K.T.; Archer, J.; Poeton, A.R.; Ryder, A. Plasma electrolytic oxidation ( PEO ) for production of anodised coatings on lightweight metal (Al, Mg, Ti) alloys. Trans. IMF 2009, 87, 122–135. [Google Scholar] [CrossRef]
- Molaei, M.; Fattah-Alhosseini, A.; Gashti, S.O. Sodium Aluminate Concentration Effects on Microstructure and Corrosion Behavior of the Plasma Electrolytic Oxidation Coatings on Pure Titanium. Metall. Mater. Trans. A Phys. Metall. Mater. Sci. 2018, 49, 368–375. [Google Scholar] [CrossRef]
- Zehra, T.; Kaseem, M.; Hossain, S.; Ko, Y.-G. Fabrication of a Protective Hybrid Coating Composed of TiO2, MoO2, and SiO2 by Plasma Electrolytic Oxidation of Titanium. Metals 2021, 11, 1182. [Google Scholar] [CrossRef]
- Nikoomanzari, E.; Karbasi, M.; Melo, W.C.M.A.; Moris, H.; Babaei, K.; Giannakis, S.; Fattah-alhosseini, A. Impressive strides in antibacterial performance amelioration of Ti-based implants via plasma electrolytic oxidation (PEO): A review of the recent advancements. Chem. Eng. J. 2022, 441, 136003. [Google Scholar] [CrossRef]
- Babaei, K.; Fattah-alhosseini, A.; Chaharmahali, R. A review on plasma electrolytic oxidation (PEO) of niobium: Mechanism, properties and applications. Surf. Interfaces 2020, 21, 100719. [Google Scholar] [CrossRef]
- Barati Darband, G.; Aliofkhazraei, M.; Hamghalam, P.; Valizade, N. Plasma electrolytic oxidation of magnesium and its alloys: Mechanism, properties and applications. J. Magnes. Alloy. 2017, 5, 74–132. [Google Scholar] [CrossRef]
- Dehnavi, V.; Shoesmith, D.W.; Luan, B.L.; Yari, M.; Liu, X.Y.; Rohani, S. Corrosion properties of plasma electrolytic oxidation coatings on an aluminium alloy—The effect of the PEO process stage. Mater. Chem. Phys. 2015, 161, 49–58. [Google Scholar] [CrossRef]
- Kaseem, M.; Choe, H.-C. Triggering the hydroxyapatite deposition on the surface of PEO-coated Ti–6Al–4V alloy via the dual incorporation of Zn and Mg ions. J. Alloys Compd. 2020, 819, 153038. [Google Scholar] [CrossRef]
- Rapheal, G.; Kumar, S.; Scharnagl, N.; Blawert, C. Effect of current density on the microstructure and corrosion properties of plasma electrolytic oxidation (PEO) coatings on AM50 Mg alloy produced in an electrolyte containing clay additives. Surf. Coat. Technol. 2016, 289, 150–164. [Google Scholar] [CrossRef]
- Dehnavi, V.; Luan, B.L.; Shoesmith, D.W.; Liu, X.Y.; Rohani, S. Effect of duty cycle and applied current frequency on plasma electrolytic oxidation (PEO) coating growth behavior. Surf. Coat. Technol. 2013, 226, 100–107. [Google Scholar] [CrossRef]
- Vakili-Azghandi, M.; Fattah-alhosseini, A. Effects of Duty Cycle, Current Frequency, and Current Density on Corrosion Behavior of the Plasma Electrolytic Oxidation Coatings on 6061 Al Alloy in Artificial Seawater. Metall. Mater. Trans. A 2017, 48, 4681–4692. [Google Scholar] [CrossRef]
- Sabaghi Joni, M.; Fattah-Alhosseini, A. Effect of KOH concentration on the electrochemical behavior of coatings formed by pulsed DC micro-arc oxidation (MAO) on AZ31B Mg alloy. J. Alloys Compd. 2016, 661, 237–244. [Google Scholar] [CrossRef]
- Barchiche, C.E.; Rocca, E.; Juers, C.; Hazan, J.; Steinmetz, J. Corrosion resistance of plasma-anodized AZ91D magnesium alloy by electrochemical methods. Electrochim. Acta 2007, 53, 417–425. [Google Scholar] [CrossRef]
- Kaseem, M.; Min, J.H.; Ko, Y.G. Corrosion behavior of Al-1wt% Mg-0.85wt%Si alloy coated by micro-arc-oxidation using TiO2 and Na2MoO4 additives: Role of current density. J. Alloys Compd. 2017, 723, 448–455. [Google Scholar] [CrossRef]
- Rakoch, A.G.; Bardin, I.V.; Kovalev, V.L.; Avanesyan, T.G. Microarc oxidation of light constructional alloys: Part 1. Main notions on the microarc oxidation of light constructional alloys. Russ. J. Non-Ferrous Met. 2013, 54, 341–344. [Google Scholar] [CrossRef]
- Farshid, S.; Kharaziha, M. Micro and nano-enabled approaches to improve the performance of plasma electrolytic oxidation coated magnesium alloys. J. Magnes. Alloy. 2021, 9, 1487–1504. [Google Scholar] [CrossRef]
- Kaseem, M.; Fatimah, S.; Nashrah, N.; Ko, Y.G. Recent progress in surface modification of metals coated by plasma electrolytic oxidation: Principle, structure, and performance. Prog. Mater. Sci. 2021, 117, 100735. [Google Scholar] [CrossRef]
- Khaselev, O.; Weiss, D.; Yahalom, J. Structure and composition of anodic films formed on binary Mg–Al alloys in KOH–aluminate solutions under continuous sparking. Corros. Sci. 2001, 43, 1295–1307. [Google Scholar] [CrossRef]
- Han, X.G.; Zhu, X.P.; Lei, M.K. Electrochemical properties of microarc oxidation films on a magnesium alloy modified by high-intensity pulsed ion beam. Surf. Coat. Technol. 2011, 206, 874–878. [Google Scholar] [CrossRef]
- Ma, Y.; Nie, X.; Northwood, D.O.; Hu, H. Corrosion and erosion properties of silicate and phosphate coatings on magnesium. Thin Solid Films 2004, 469–470, 472–477. [Google Scholar] [CrossRef]
- Shang, W.; Chen, B.; Shi, X.; Chen, Y.; Xiao, X. Electrochemical corrosion behavior of composite MAO/sol–gel coatings on magnesium alloy AZ91D using combined micro-arc oxidation and sol–gel technique. J. Alloys Compd. 2009, 474, 541–545. [Google Scholar] [CrossRef]
- Xue, W.; Deng, Z.; Chen, R.; Zhang, T. Growth regularity of ceramic coatings formed by microarc oxidation on Al–Cu–Mg alloy. Thin Solid Films 2000, 372, 114–117. [Google Scholar] [CrossRef]
- Mu, W.; Han, Y. Characterization and properties of the MgF2/ZrO2 composite coatings on magnesium prepared by micro-arc oxidation. Surf. Coat. Technol. 2008, 202, 4278–4284. [Google Scholar] [CrossRef]
- Kaseem, M.; Hussain, T.; Rehman, Z.U.; Ko, Y.G. Stabilization of AZ31 Mg alloy in sea water via dual incorporation of MgO and WO3 during micro-arc oxidation. J. Alloys Compd. 2021, 853, 157036. [Google Scholar] [CrossRef]
- Hua, Y.; Zhang, Z.; Li, W. Microstructure and degradation properties of C-containing composite coatings on magnesium alloy wires treated with micro-arc oxidation. Surf. Coat. Technol. 2016, 291, 70–78. [Google Scholar] [CrossRef]
- Gu, X.N.; Zheng, Y.F.; Lan, Q.X.; Cheng, Y.; Zhang, Z.X.; Xi, T.F.; Zhang, D.Y. Surface modification of an Mg-1Ca alloy to slow down its biocorrosion by chitosan. Biomed. Mater. 2009, 4, 044109. [Google Scholar] [CrossRef]
- Dai, Y.L.; Yu, K.; Chen, L.J.; Chen, C.; Qiao, X.Y.; Yan, Y. In vitro corrosion behavior and cytotoxicity property of magnesium matrix composite with chitosan coating. J. Cent. South Univ. 2015, 22, 829–834. [Google Scholar] [CrossRef]
- Yu, C.; Cui, L.-Y.; Zhou, Y.-F.; Han, Z.-Z.; Chen, X.-B.; Zeng, R.-C.; Zou, Y.-H.; Li, S.-Q.; Zhang, F.; Han, E.-H.; et al. Self-degradation of micro-arc oxidation/chitosan composite coating on Mg-4Li-1Ca alloy. Surf. Coat. Technol. 2018, 344, 1–11. [Google Scholar] [CrossRef]
- Zeng, R.-C.; Cui, L.; Jiang, K.; Liu, R.; Zhao, B.-D.; Zheng, Y.-F. In Vitro Corrosion and Cytocompatibility of a Microarc Oxidation Coating and Poly(l-lactic acid) Composite Coating on Mg–1Li–1Ca Alloy for Orthopedic Implants. ACS Appl. Mater. Interfaces 2016, 8, 10014–10028. [Google Scholar] [CrossRef]
- Li, L.-H.; Sankara Narayanan, T.S.N.; Kim, Y.K.; Kong, Y.-M.; Park, I.S.; Bae, T.S.; Lee, M.H. Deposition of microarc oxidation–polycaprolactone duplex coating to improve the corrosion resistance of magnesium for biodegradable implants. Thin Solid Films 2014, 562, 561–567. [Google Scholar] [CrossRef]
- Kim, Y.-K.; Lee, K.-B.; Kim, S.-Y.; Jang, Y.-S.; Kim, J.H.; Lee, M.-H. Improvement of osteogenesis by a uniform PCL coating on a magnesium screw for biodegradable applications. Sci. Rep. 2018, 8, 13264. [Google Scholar] [CrossRef]
- Santos-Coquillat, A.; Martínez-Campos, E.; Vargas-Alfredo, N.; Arrabal, R.; Rodríguez-Hernández, J.; Matykina, E. Hierarchical Functionalized Polymeric-Ceramic Coatings on Mg-Ca Alloys for Biodegradable Implant Applications. Macromol. Biosci. 2019, 19, 1–9. [Google Scholar] [CrossRef] [PubMed]
- Calejo, M.T.; Ilmarinen, T.; Skottman, H.; Kellomäki, M. Breath figures in tissue engineering and drug delivery: State-of-the-art and future perspectives. Acta Biomater. 2018, 66, 44–66. [Google Scholar] [CrossRef] [PubMed]
- Chen, Y.; Song, Y.; Zhang, S.; Li, J.; Zhao, C.; Zhang, X. Interaction between a high purity magnesium surface and PCL and PLA coatings during dynamic degradation. Biomed. Mater. 2011, 6, 025005. [Google Scholar] [CrossRef] [PubMed]
- Ostrowski, N.J.; Lee, B.; Roy, A.; Ramanathan, M.; Kumta, P.N. Biodegradable poly(lactide-co-glycolide) coatings on magnesium alloys for orthopedic applications. J. Mater. Sci. Mater. Med. 2013, 24, 85–96. [Google Scholar] [CrossRef]
- Middleton, J.C.; Tipton, A.J. Synthetic biodegradable polymers as orthopedic devices. Biomaterials 2000, 21, 2335–2346. [Google Scholar] [CrossRef]
- Li, J.N.; Cao, P.; Zhang, X.N.; Zhang, S.X.; He, Y.H. In vitro degradation and cell attachment of a PLGA coated biodegradable Mg–6Zn based alloy. J. Mater. Sci. 2010, 45, 6038–6045. [Google Scholar] [CrossRef]
- Abdal-hay, A.; Barakat, N.A.M.; Lim, J.K. Influence of electrospinning and dip-coating techniques on the degradation and cytocompatibility of Mg-based alloy. Colloids Surfaces A Physicochem. Eng. Asp. 2013, 420, 37–45. [Google Scholar] [CrossRef]
- Tian, P.; Xu, D.; Liu, X. Mussel-inspired functionalization of PEO/PCL composite coating on a biodegradable AZ31 magnesium alloy. Colloids Surf. B Biointerfaces 2016, 141, 327–337. [Google Scholar] [CrossRef]
- Heise, S.; Virtanen, S.; Boccaccini, A.R. Tackling Mg alloy corrosion by natural polymer coatings-A review. J. Biomed. Mater. Res. Part A 2016, 104, 2628–2641. [Google Scholar] [CrossRef]
- Li, L.-H.; Narayanan, T.S.N.; Kim, Y.K.; Kong, Y.-M.; Shin, G.-S.; Lyu, S.-K.; Park, I.S.; Lee, M.H. Coloring and corrosion resistance of pure Mg modified by micro-arc oxidation method. Int. J. Precis. Eng. Manuf. 2014, 15, 1625–1630. [Google Scholar] [CrossRef]
- Adhikari, U.; Rijal, N.P.; Khanal, S.; Pai, D.; Sankar, J.; Bhattarai, N. Magnesium incorporated chitosan based scaffolds for tissue engineering applications. Bioact. Mater. 2016, 1, 132–139. [Google Scholar] [CrossRef] [PubMed]
- Delezuk, J.A.M.; Ramírez-Herrera, D.E.; Esteban-Fernández de Ávila, B.; Wang, J. Chitosan-based water-propelled micromotors with strong antibacterial activity. Nanoscale 2017, 9, 2195–2200. [Google Scholar] [CrossRef] [PubMed]
- Kunjukunju, S.; Roy, A.; Ramanathan, M.; Lee, B.; Candiello, J.E.; Kumta, P.N. A layer-by-layer approach to natural polymer-derived bioactive coatings on magnesium alloys. Acta Biomater. 2013, 9, 8690–8703. [Google Scholar] [CrossRef] [PubMed]
- Bai, K.; Zhang, Y.; Fu, Z.; Zhang, C.; Cui, X.; Meng, E.; Guan, S.; Hu, J. Fabrication of chitosan/magnesium phosphate composite coating and the in vitro degradation properties of coated magnesium alloy. Mater. Lett. 2012, 73, 59–61. [Google Scholar] [CrossRef]
- Patrick, J.F.; Robb, M.J.; Sottos, N.R.; Moore, J.S.; White, S.R. Polymers with autonomous life-cycle control. Nature 2016, 540, 363–370. [Google Scholar] [CrossRef] [PubMed]
- Pramanik, N.B.; Mondal, P.; Mukherjee, R.; Singha, N.K. A new class of self-healable hydrophobic materials based on ABA triblock copolymer via RAFT polymerization and Diels-Alder “click chemistry”. Polymer 2017, 119, 195–205. [Google Scholar] [CrossRef]
- Jia, Z.; Xiong, P.; Shi, Y.; Zhou, W.; Cheng, Y.; Zheng, Y.; Xi, T.; Wei, S. Inhibitor encapsulated, self-healable and cytocompatible chitosan multilayer coating on biodegradable Mg alloy: A pH-responsive design. J. Mater. Chem. B 2016, 4, 2498–2511. [Google Scholar] [CrossRef]
- Zeng, R.-C.; Li, X.-T.; Liu, Z.-G.; Zhang, F.; Li, S.-Q.; Cui, H.-Z. Corrosion resistance of Zn–Al layered double hydroxide/poly(lactic acid) composite coating on magnesium alloy AZ31. Front. Mater. Sci. 2015, 9, 355–365. [Google Scholar] [CrossRef]
- Zhou, H.; Lawrence, J.G.; Bhaduri, S.B. Fabrication aspects of PLA-CaP/PLGA-CaP composites for orthopedic applications: A review. Acta Biomater. 2012, 8, 1999–2016. [Google Scholar] [CrossRef]
- Li, X.; Chu, C.; Wei, Y.; Qi, C.; Bai, J.; Guo, C.; Xue, F.; Lin, P.; Chu, P.K. In vitro degradation kinetics of pure PLA and Mg/PLA composite: Effects of immersion temperature and compression stress. Acta Biomater. 2017, 48, 468–478. [Google Scholar] [CrossRef]
- Shi, Y.; Pei, J.; Zhang, J.; Niu, J.; Zhang, H.; Guo, S.; Li, Z.; Yuan, G. Enhanced corrosion resistance and cytocompatibility of biodegradable Mg alloys by introduction of Mg(OH)2 particles into poly (L-lactic acid) coating. Sci. Rep. 2017, 7, 41796. [Google Scholar] [CrossRef] [PubMed]
- Butt, M.S.; Bai, J.; Wan, X.; Chu, C.; Xue, F.; Ding, H.; Zhou, G. Mg alloy rod reinforced biodegradable poly-lactic acid composite for load bearing bone replacement. Surf. Coat. Technol. 2017, 309, 471–479. [Google Scholar] [CrossRef]
- Farah, S.; Anderson, D.G.; Langer, R. Physical and mechanical properties of PLA, and their functions in widespread applications—A comprehensive review. Adv. Drug Deliv. Rev. 2016, 107, 367–392. [Google Scholar] [CrossRef] [PubMed]
- Song, Y.; Li, Y.; Song, W.; Yee, K.; Lee, K.-Y.; Tagarielli, V.L. Measurements of the mechanical response of unidirectional 3D-printed PLA. Mater. Des. 2017, 123, 154–164. [Google Scholar] [CrossRef]
- Lu, P.; Cao, L.; Liu, Y.; Xu, X.; Wu, X. Evaluation of magnesium ions release, biocorrosion, and hemocompatibility of MAO/PLLA-modified magnesium alloy WE42. J. Biomed. Mater. Res. Part B Appl. Biomater. 2011, 96B, 101–109. [Google Scholar] [CrossRef]
- Alabbasi, A.; Liyanaarachchi, S.; Kannan, M.B. Polylactic acid coating on a biodegradable magnesium alloy: An in vitro degradation study by electrochemical impedance spectroscopy. Thin Solid Films 2012, 520, 6841–6844. [Google Scholar] [CrossRef]
- Alabbasi, A.; Mehjabeen, A.; Kannan, M.B.; Ye, Q.; Blawert, C. Biodegradable polymer for sealing porous PEO layer on pure magnesium: An in vitro degradation study. Appl. Surf. Sci. 2014, 301, 463–467. [Google Scholar] [CrossRef]
- Shi, P.; Niu, B.; Shanshan, E.; Chen, Y.; Li, Q. Preparation and characterization of PLA coating and PLA/MAO composite coatings on AZ31 magnesium alloy for improvement of corrosion resistance. Surf. Coat. Technol. 2015, 262, 26–32. [Google Scholar] [CrossRef]
- Bakhsheshi-Rad, H.R.; Hamzah, E.; Ebrahimi-Kahrizsangi, R.; Daroonparvar, M.; Medraj, M. Fabrication and characterization of hydrophobic microarc oxidation/poly-lactic acid duplex coating on biodegradable Mg–Ca alloy for corrosion protection. Vacuum 2016, 125, 185–188. [Google Scholar] [CrossRef]
- Tomihata, K.; Suzuki, M.; Ikada, Y. The pH dependence of monofilament sutures on hydrolytic degradation. J. Biomed. Mater. Res. 2001, 58, 511–518. [Google Scholar] [CrossRef]
- Yazdimamaghani, M.; Razavi, M.; Vashaee, D.; Tayebi, L. Surface modification of biodegradable porous Mg bone scaffold using polycaprolactone/bioactive glass composite. Mater. Sci. Eng. C 2015, 49, 436–444. [Google Scholar] [CrossRef]
- Vandrovcova, M.; Douglas, T.E.L.; Mróz, W.; Musial, O.; Schaubroeck, D.; Budner, B.; Syroka, R.; Dubruel, P.; Bacakova, L. Pulsed laser deposition of magnesium-doped calcium phosphate coatings on porous polycaprolactone scaffolds produced by rapid prototyping. Mater. Lett. 2015, 148, 178–183. [Google Scholar] [CrossRef]
- Wong, H.M.; Zhao, Y.; Leung, F.K.L.; Xi, T.; Zhang, Z.; Zheng, Y.; Wu, S.; Luk, K.D.K.; Cheung, K.M.C.; Chu, P.K.; et al. Functionalized Polymeric Membrane with Enhanced Mechanical and Biological Properties to Control the Degradation of Magnesium Alloy. Adv. Healthc. Mater. 2017, 6, 1601269. [Google Scholar] [CrossRef] [PubMed]
- Domingos, M.; Intranuovo, F.; Gloria, A.; Gristina, R.; Ambrosio, L.; Bártolo, P.J.; Favia, P. Improved osteoblast cell affinity on plasma-modified 3-D extruded PCL scaffolds. Acta Biomater. 2013, 9, 5997–6005. [Google Scholar] [CrossRef] [PubMed]
- Dash, T.K.; Konkimalla, V.B. Poly-є-caprolactone based formulations for drug delivery and tissue engineering: A review. J. Control. Release 2012, 158, 15–33. [Google Scholar] [CrossRef]
- Labet, M.; Thielemans, W. Synthesis of polycaprolactone: A review. Chem. Soc. Rev. 2009, 38, 3484. [Google Scholar] [CrossRef]
- Bosworth, L.A.; Downes, S. Physicochemical characterisation of degrading polycaprolactone scaffolds. Polym. Degrad. Stab. 2010, 95, 2269–2276. [Google Scholar] [CrossRef]
- Dash, T.K.; Konkimalla, V.B. Polymeric Modification and Its Implication in Drug Delivery: Poly-ε-caprolactone (PCL) as a Model Polymer. Mol. Pharm. 2012, 9, 2365–2379. [Google Scholar] [CrossRef]
- Mamaghani, M.Y.; Pishvaei, M.; Kaffashi, B. Synthesis of latex based antibacterial acrylate polymer/nanosilver via in situ miniemulsion polymerization. Macromol. Res. 2011, 19, 243–249. [Google Scholar] [CrossRef]
- Brown, A.; Zaky, S.; Ray, H.; Sfeir, C. Porous magnesium/PLGA composite scaffolds for enhanced bone regeneration following tooth extraction. Acta Biomater. 2015, 11, 543–553. [Google Scholar] [CrossRef]
- Chen, L.; Sheng, Y.; Zhou, H.; Li, Z.; Wang, X.; Li, W. Influence of a MAO + PLGA coating on biocorrosion and stress corrosion cracking behavior of a magnesium alloy in a physiological environment. Corros. Sci. 2019, 148, 134–143. [Google Scholar] [CrossRef]
- Hatami, M.; Saremi, M.; Naderi, R. Improvement in the protective performance and adhesion of polypyrrole coating on AZ31 Mg alloys. Prog. Nat. Sci. Mater. Int. 2015, 25, 478–485. [Google Scholar] [CrossRef]
- Gnedenkov, S.V.; Sinebryukhov, S.L.; Zavidnaya, A.G.; Egorkin, V.S.; Puz’, A.V.; Mashtalyar, D.V.; Sergienko, V.I.; Yerokhin, A.L.; Matthews, A. Composite hydroxyapatite-PTFE coatings on Mg-Mn-Ce alloy for resorbable implant applications via a plasma electrolytic oxidation-based route. J. Taiwan Inst. Chem. Eng. 2014, 45, 3104–3109. [Google Scholar] [CrossRef]
- Xu, X.; Lu, P.; Guo, M.; Fang, M. Cross-linked gelatin/nanoparticles composite coating on micro-arc oxidation film for corrosion and drug release. Appl. Surf. Sci. 2010, 256, 2367–2371. [Google Scholar] [CrossRef]
- Du, M.; Huang, L.; Peng, M.; Hu, F.; Gao, Q.; Chen, Y.; Liu, P. Preparation of vancomycin-loaded alginate hydrogel coating on magnesium alloy with enhanced anticorrosion and antibacterial properties. Thin Solid Films 2020, 693, 137679. [Google Scholar] [CrossRef]
- Zeng, R.; Liu, L.; Luo, K.; Shen, L.; Zhang, F.; Li, S.; Zou, Y. In vitro corrosion and antibacterial properties of layer-by-layer assembled GS/PSS coating on AZ31 magnesium alloys. Trans. Nonferrous Met. Soc. China 2015, 25, 4028–4039. [Google Scholar] [CrossRef]
- Robinson, D.A.; Griffith, R.W.; Shechtman, D.; Evans, R.B.; Conzemius, M.G. In vitro antibacterial properties of magnesium metal against Escherichia coli, Pseudomonas aeruginosa and Staphylococcus aureus. Acta Biomater. 2010, 6, 1869–1877. [Google Scholar] [CrossRef]
- Zhang, Y.; Feyerabend, F.; Tang, S.; Hu, J.; Lu, X.; Blawert, C.; Lin, T. A study of degradation resistance and cytocompatibility of super-hydrophobic coating on magnesium. Mater. Sci. Eng. C 2017, 78, 405–412. [Google Scholar] [CrossRef]
- Tian, P.; Peng, F.; Wang, D.; Liu, X. Corrosion behavior and cytocompatibility of fluoride-incorporated plasma electrolytic oxidation coating on biodegradable AZ31 alloy. Regen. Biomater. 2017, 4, 1–10. [Google Scholar] [CrossRef]
- Kubo, K.; Tsukimura, N.; Iwasa, F.; Ueno, T.; Saruwatari, L.; Aita, H.; Chiou, W.-A.; Ogawa, T. Cellular behavior on TiO2 nanonodular structures in a micro-to-nanoscale hierarchy model. Biomaterials 2009, 30, 5319–5329. [Google Scholar] [CrossRef]
- Muñoz-Bonilla, A.; Fernández-García, M.; Rodríguez-Hernández, J. Towards hierarchically ordered functional porous polymeric surfaces prepared by the breath figures approach. Prog. Polym. Sci. 2014, 39, 510–554. [Google Scholar] [CrossRef]
- Mukherjee, P.K. Bioassay-Guided Isolation and Evaluation of Herbal Drugs. In Quality Control and Evaluation of Herbal Drugs; Elsevier: Amsterdam, The Netherlands, 2019; pp. 515–537. [Google Scholar]
- Wei, Z.; Tian, P.; Liu, X.; Zhou, B. Hemocompatibility and selective cell fate of polydopamine-assisted heparinized PEO/PLLA composite coating on biodegradable AZ31 alloy. Colloids Surf. B Biointerfaces 2014, 121, 451–460. [Google Scholar] [CrossRef] [PubMed]
- Lu, P.; Fan, H.; Liu, Y.; Cao, L.; Wu, X.; Xu, X. Controllable biodegradability, drug release behavior and hemocompatibility of PTX-eluting magnesium stents. Colloids Surf. B Biointerfaces 2011, 83, 23–28. [Google Scholar] [CrossRef] [PubMed]

| Substrate | Polymer Layer | Corrosive Media | Time | Ecorr (V) | icorr (A.cm−2) | Rp (Ω.cm2) | Ref. |
|---|---|---|---|---|---|---|---|
| Mg-4Li-1Ca | Chitosan | Hank’s solution | 13 min | −1.93 | 6.71 × 10-6 | - | [112] |
| Pure Mg | Polycaprolactone (PCL) | SBF | 3 months | - | - | - | [115] |
| Pure Mg | Poly(l-lactide) (PLLA) | SBF | 2 h | −1.54 | 3 × 10−8 | 105 | [142] |
| Pure Mg | Polycaprolactone (PCL) | HBSS | 7 days | −1.53 | 81 × 10–8 | 9.9 × 103 | [114] |
| Mg–Mn–Ce | Polytetrafluoroethylene (SPTFE) | 3 wt.% NaCl | 30 min | −1.50 | 5.4 × 10−9 | 1 × 107 | [158] |
| WE42 | Gelatin | Hank’s solution | - | −1.42 | 9 × 10–7 | - | [159] |
| AZ31 | Polyethyleneimine (PEI) | SBF | - | −0.31 | 3.34 × 10−7 | - | [160] |
Publisher’s Note: MDPI stays neutral with regard to jurisdictional claims in published maps and institutional affiliations. |
© 2022 by the authors. Licensee MDPI, Basel, Switzerland. This article is an open access article distributed under the terms and conditions of the Creative Commons Attribution (CC BY) license (https://creativecommons.org/licenses/by/4.0/).
Share and Cite
Fattah-alhosseini, A.; Chaharmahali, R.; Rajabi, A.; Babaei, K.; Kaseem, M. Performance of PEO/Polymer Coatings on the Biodegradability, Antibacterial Effect and Biocompatibility of Mg-Based Materials. J. Funct. Biomater. 2022, 13, 267. https://doi.org/10.3390/jfb13040267
Fattah-alhosseini A, Chaharmahali R, Rajabi A, Babaei K, Kaseem M. Performance of PEO/Polymer Coatings on the Biodegradability, Antibacterial Effect and Biocompatibility of Mg-Based Materials. Journal of Functional Biomaterials. 2022; 13(4):267. https://doi.org/10.3390/jfb13040267
Chicago/Turabian StyleFattah-alhosseini, Arash, Razieh Chaharmahali, Armin Rajabi, Kazem Babaei, and Mosab Kaseem. 2022. "Performance of PEO/Polymer Coatings on the Biodegradability, Antibacterial Effect and Biocompatibility of Mg-Based Materials" Journal of Functional Biomaterials 13, no. 4: 267. https://doi.org/10.3390/jfb13040267
APA StyleFattah-alhosseini, A., Chaharmahali, R., Rajabi, A., Babaei, K., & Kaseem, M. (2022). Performance of PEO/Polymer Coatings on the Biodegradability, Antibacterial Effect and Biocompatibility of Mg-Based Materials. Journal of Functional Biomaterials, 13(4), 267. https://doi.org/10.3390/jfb13040267

